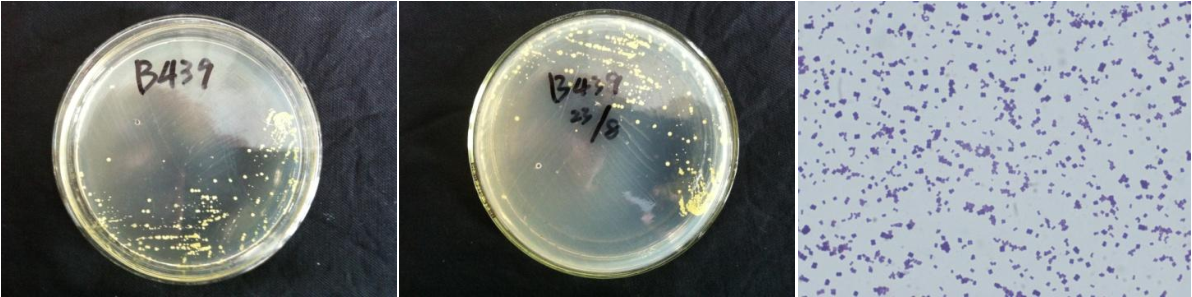

Loading...
| StrainNO | B439 |
| Classification | Micrococcus |
| 16s rDNA sequence | GGGGGGGGTCACCCTTCGACGGCTCCCTCCACAAGGGTTAGGCCACCGGCTTCGGGTGTTACCGACTTTCGTGACTTGACGGGCG GTGTGTACAAGGCCCGGGAACGTATTCACCGCAGCGTTGCTGATCTGCGATTACTAGCGACTCCGACTTCATGGGGTCGAGTTGC AGACCCCAATCCGAACTGAGACCGGCTTTTTGGGATTAGCTCCACCTCACAGTATCGCAACCCATTGTACCGGCCATTGTAGCAT GCGTGAAGCCCAAGACATAAGGGGCATGATGATTTGACGTCGTCCCCACCTTCCTCCGAGTTGACCCCGGCAGTCTCCCATGAGT CCCCACCCGAAGTGCTGGCAACATGGAACGAGGGTTGCGCTCGTTGCGGGACTTAACCCAACATCTCACGACACGAGCTGACGAC AACCATGCACCACCTGTGAACCCGCCCCAAAGGGGAAACCGTATCTCTACGGCGATCGAGAACATGTCAAGCCTTGGTAAGGTTC TTCGCGTTGCATCGAATTAATCCGCATGCTCCGCCGCTTGTGCGGGCCCCCGTCAATTCCTTTGAGTTTTAGCCTTGCGGCCGTA CTCCCCAGGCGGGGCACTTAATGCGTTAGCTGCGGCGCGGAAAACGTGGAATGTTCCCCACACCTAGTGCCCAACGTTTACGGCA TGGACTACCAGGGTATCTAATCCTGTTCGCTCCCCATGCTTTCGCTCCTCAGCGTCAGTTACAGCCCAGAGACCTGCCTTCGCCA TCGGTGTTCCTCCTGATATCTGCGCATTCCACCGCTACACCAGGAATTCCAGTCTCCCCTACTGCACTCTAGTCTGCCCGTACCC ACCGCAGATCCGGGGTTAAGCCCCGGACTTTCACGACAGACGCGACAAACCGCCTACGAGCTCTTTACGCCCAATAATTCCGGAT AACGCTCGCACCCTACGTATTACCGCGGCTGCTGGCACGTAGTTAGCCGGTGCTTCTTCTGCAGGTACCGTCACTTTCGCTTCTT CCCTACTGAAAGAGGTTTACAACCCGAAGGCCGTCATCCCTCACGCGGCGTCGCTGCATCAGGCTTTCGCCCATTGTGCAATATT CCCCACTGCTGCCTCCCGTAGGAGTCTGGGCCGTGTCTCAGTCCCAGTGTGGCCGGTCACCCTCTCAGGCCGGCTACCCGTCGTC GCCTTGGTGAGCCATTACCTCACCAACAAGCTGATAGGCCGCGAGTCCATCCATGACCGAAATTCTTTCCAACATCCACCATGCG GTAGACGTTCCTATCCAGTATTAGACCCAGTTTCCCGGGCTTATCCTAGAGTCAAGGGCAGGTTACTCACGTGTTACTCACCCGT TCGCCACTAATCCACCCAGCAAGCTGGGCTTCATCGTTCGACTTGCATGGTAGCATGCCCCCCC |
| Strain Morphology Photos | |
| Morphological Description | The morphology of Colony round;light-yellow;edge neatly;steamed bun shaped;slippy;sticky;The morphology of strain:spherical;no spore |